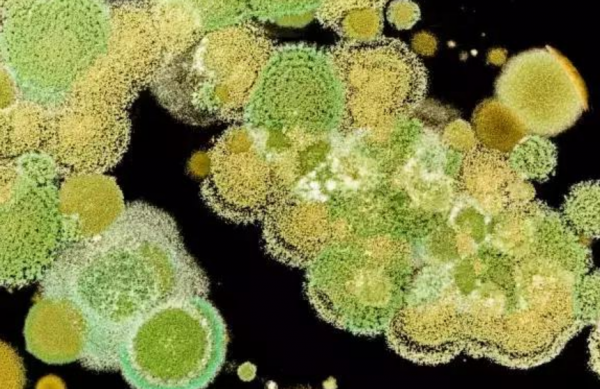

在我们的日常生活中,很多健康问题往往在不经意间透露出警示信号,而我们的腿部,竟然可能就是肝硬化这一严重健康问题的"放大镜"。
肝硬化是一种严重的肝脏疾病,由肝细胞长期受损导致肝脏逐渐丧失功能,形成疤痕组织。
由于肝脏在我们体内扮演着多种生理功能的角色,肝硬化的发展会引发一系列系统性的健康问题,而腿部的某些异常现象,往往是这种疾病最初的外在表现。

张先生的不寻常周末
张先生的周末原本计划是在家中放松,享受他最喜爱的历史书籍。他热爱阅读,尤其是那些描写古代战役和战略的书籍。他的家里布置得十分舒适,客厅里摆满了从世界各地收集来的艺术品,墙上挂着精致的古地图和复古风格的钟表。
周六下午,他在沉浸在《三国演义》的波澜壮阔时,突然感到右腿脚踝附近有些不适。起初,他以为只是坐得太久,血液循环有些不畅。他尝试走动,希望可以缓解不适,但疼痛并未如期消退。

到了晚上,他的腿部不仅没有好转,反而肿胀加剧,连轻轻触碰都让他感到疼痛。张先生决定用冰袋敷腿,试图缓解肿胀和疼痛。他小心翼翼地把冰袋放在脚踝上,然后尽量不去动它。尽管如此,疼痛感似乎更加强烈了。
第二天,张先生的腿肿得更严重了,肿胀部位的皮肤开始变得发亮,甚至显现出一种不正常的红色。这种情况让他意识到问题可能比较严重。他撑着疼痛,打电话给了一位朋友,请他帮忙开车送他去医院。

在医院,经过一系列的检查和测试,医生告诉张先生,他的症状是由肝硬化引起的严重并发症。医生解释说,肝硬化导致的血液循环问题使得血液中的液体成分渗透到周围组织中,造成了腿部的肿胀和疼痛。
此外,医生还指出张先生腿部皮肤的颜色改变是因为血管受到压迫,影响了血液的正常流动。

张先生被安排住院治疗,医生为他制定了一套综合治疗方案,包括药物治疗和生活方式的调整。在医生和护士的精心照料下,他的症状逐渐得到控制。张先生也开始认真思考自己的健康,决定在康复后调整饮食习惯和生活方式,避免此类健康问题再次发生。
全球肝癌患者,中国人占一半
肝癌,这一位列全球癌症死亡率前列的恶性肿瘤,在中国的发病率尤为惊人。据统计,全球每年新发肝癌病例中,约有一半发生在中国。这一数字不仅反映了肝癌在中国的严峻形势,也揭示了多种复杂因素的叠加效应。

为何中国的肝癌病例会如此之多?首先,病毒性肝炎的高患病率是主要原因之一。在中国,乙型和丙型肝炎病毒的感染率远高于世界其他地区。
这两种病毒的慢性感染是导致肝硬化及随后发展为肝癌的重要因素。长期以来,由于缺乏有效的疾病防控与普及教育,病毒性肝炎的传播和感染问题一直未能得到根本解决。

此外,中国的食品安全问题也为肝癌的高发提供了"温床"。霉变食物中常含有黄曲霉毒素,这种强致癌物质能直接损害肝细胞的DNA,增加肝癌的发病风险。在某些地区,由于储存条件不当和对食品安全的忽视,黄曲霉毒素污染尤为严重。
环境污染也不容忽视。中国快速的工业化进程带来了严重的环境问题,包括空气和水污染。这些因素中含有的有害物质,如重金属和工业溶剂,都已被证实与肝癌的发生有关。

那么,针对这一病情严峻的现状,中国在防治肝癌方面采取了哪些措施?近年来,中国政府加大了对肝炎防治的投入,推广乙型肝炎疫苗接种,有效减少了病毒性肝炎的新发感染率。
同时,食品安全法规和标准得到了加强,尤其是在食品储存和加工环节,对防止霉变和黄曲霉毒素污染进行了严格的控制。
在公共卫生教育方面,通过提高公众对肝癌风险因素的认识,增强自我保护意识,也是减少肝癌发病率的重要策略。国家和地方政府举办的健康教育活动,以及社区健康讲座,都在努力提高人们的健康知识水平,特别是在肝病防治方面。
尽管面临诸多挑战,但通过这些综合性的措施,中国在降低肝癌的发病率和死亡率方面取得了一定的进展。然而,要根本扭转这一局面,还需持续的努力和更多有效的政策支持。

腿上若出现这3种异常,赶快去医院
持续性的腿部肿胀
如果你的腿部,特别是小腿和脚踝部位出现持续的肿胀,这可能是血液循环问题的信号。在很多情况下,这种肿胀可能与心脏功能不全有关,因为心脏无法有效地泵送血液,导致血液在腿部静脉中回流不畅,引起积液。
此外,腿部持续肿胀还可能是肾脏问题或淋巴系统功能障碍的表现。这种情况下,肿胀通常会在晚上加重,而在早上醒来时减轻。如果伴随有皮肤颜色变化或肿胀部位疼痛加剧,应立即寻求医疗帮助。

腿部皮肤颜色异常
腿部出现皮肤颜色变化,尤其是变得异常红润或呈现青紫色,这可能是血管阻塞或炎症的迹象。静脉炎或深静脉血栓形成时,血管被阻塞,血液无法正常流动,会导致腿部皮肤颜色变化,并伴有疼痛和触摸温度升高。
腿部疼痛伴随走路困难
如果你在行走时感到腿部疼痛,尤其是伴有走路困难或无力感,这可能是周围动脉疾病的警告信号。

周围动脉疾病是由于腿部动脉堵塞或狭窄,导致肌肉无法获得足够的血液供应,尤其在活动时更明显。这种病症如果不加治疗,可能会逐步恶化,严重时甚至导致组织坏死或需要截肢。
以上这些腿部异常现象都不应被忽视,它们可能是身体发出的求救信号。定期检查和及时的医疗干预可以有效预防这些症状带来的严重后果。保持健康的生活方式,如均衡饮食、适量运动和避免长时间静坐或站立,同样对预防腿部问题至关重要。










